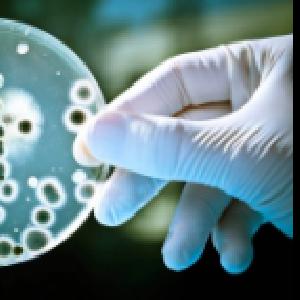

Новини
Сибірка: як розпізнати небезпечну хворобу у тварин
 Сибірка - одна з найнебезпечніших зоонозних інфекцій, яка здатна блискавично уражати як тварин, так і людину. Саме тому швидка реакція - ключ до збереження здоров’я та уникнення поширення хвороби.
Сибірка - одна з найнебезпечніших зоонозних інфекцій, яка здатна блискавично уражати як тварин, так і людину. Саме тому швидка реакція - ключ до збереження здоров’я та уникнення поширення хвороби.
Які симптоми мають насторожити?
• різке пригнічення, втрата апетиту;
• підвищення температури тіла;
• щільні болючі набряки;
• поява піни чи виділень із домішками крові з рота або носа;
• кров’янисті виділення з природних отворів;
• раптова загибель тварини без видимих передумов.
У багатьох випадках захворювання прогресує настільки стрімко, що прояви можуть розвинутися протягом кількох годин.
 Якщо є підозра на сибірку - негайно звертайтеся до територіального підрозділу Держпродспоживслужби за місцем розташування господарства. Швидке інформування дозволяє запобігти подальшому поширенню збудника.
Якщо є підозра на сибірку - негайно звертайтеся до територіального підрозділу Держпродспоживслужби за місцем розташування господарства. Швидке інформування дозволяє запобігти подальшому поширенню збудника.
 Детальніше - в інфографіці, підготовленій у співпраці з європейським проєктом EU4SaferFood.
Детальніше - в інфографіці, підготовленій у співпраці з європейським проєктом EU4SaferFood.
#Anthrax #Сибірка #Zoonoses #ЗдоровʼяТварин #FoodSafety
